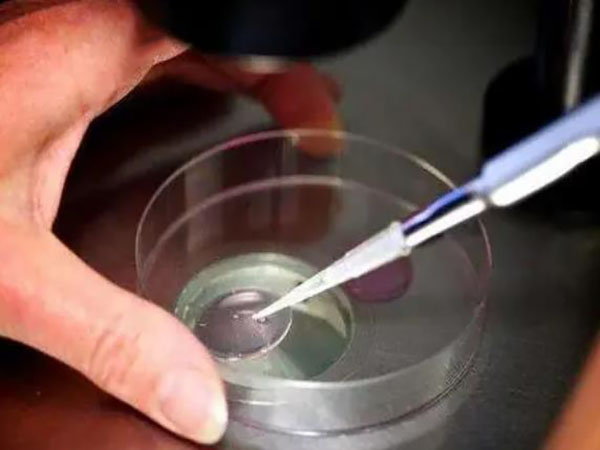

寶寶反覆溼疹是過敏體質嗎?反覆溼疹怎麼治療效果好?
寶寶眼下溼疹一直反覆不好有很大可能是過敏體質。這種情況寶寶如果有癢的感覺,可以給寶寶塗個保溼乳或身體乳。溼疹它發病的原因主要就是面板粘膜屏障功能不成熟所導致的。這樣不成熟的情況下,面板這個表面它的角質層,並不是很牢固所以就會導致皮下的水分丟失。在一些物理和化學驗收的刺激下呢,它就可以誘發溼疹。這種情況建議用一下保溼霜,每天多擦幾次,擦的時候擦厚一點。如果寶寶這個皮疹有癢的感覺,影響到寶寶睡眠的情況...

寶寶溼疹最怕的三個土辦法:輕鬆止癢遠離紅疹效果佳
嬰兒溼疹最怕的三個土辦法分別是用土豆片塗抹、金銀花水洗澡、清瀝草煮水這些方法。其實除此之外,民間還有很多土方法,如中藥泡澡洗、茶葉水和茶油等方法,當然其中最重要的就是寶寶的飲食了,寶媽可以用紅豆、黑豆、綠豆中的任何一種或幾種煮粥,或者用冬瓜做湯,這樣可以預防或緩解嬰兒的溼疹。且嬰兒得溼疹主要是因為對食物、環境或接觸物不耐受或過敏所致,所以要想避免嬰兒溼疹,最好的辦法就是孩子一出生就選擇純母乳餵養,...

嬰兒全身長溼疹多半是過敏,教你3招輕鬆應對不用愁
寶寶長溼疹可能是過敏導致的,也可能是其他原因。首先要做的就是及時就醫,以確診到底是什麼原因導致的,以便採取有效的方法進行治療。就醫時,家長需要提供寶寶的詳細身體情況,如寶寶的症狀和發病時間,這樣可以有效的幫助醫生快速診斷出寶寶的病情,並給出有效的治療方案。寶寶全身長溼疹的緩解方法區域性處理主要是做好區域性的面板護理,注意給寶寶洗臉、洗澡要控制時間,不要太久,水溫也不要太熱,洗完之後需要儘快擦乾,還可以...

試管嬰兒移植後早孕徵兆一覽,長溼疹真心不在其列
囊胚移植後成功的早孕徵兆並不包含長溼疹的症狀,所以患者在移植後出現長溼疹癢得厲害並不代表成功了,可能是由於生活環境不衛生導致的,也可能是身體排斥藥物導致出現溼疹情況,因此患者在出現溼疹時一定要及時就醫,並在醫生的指導下采取干預措施,避免溼疹的瘙癢加重而導致囊胚移植的失敗,同時患者還要注意保持面板清潔、保持情緒穩定,以免影響囊胚的正常生長髮育情況。移植後長溼疹是什麼原因對於囊胚移植是否成功是不能單純...
常見的溼疹型別分五種,每一種表現均不同!
溼疹是一種常見的面板病,可能是過敏引起的,也有可能是遺傳導致的,或者是後天形成的,它的種類是比較多的,預防和治療的方式都是不一樣的。而且現目前很多的人是分不清溼疹,所以經常單純性的一位是過敏,或者是天氣熱所導致的,從而治療,從而引發一些不良後果,今天就為大家深入的瞭解溼疹的各種形態,讓大家很好的區分其型別。常見溼疹分為五種型別其實很多人都不知道溼疹可以細分為5種類型的,不同的型別其症狀、表現出來的...

一招區別尿布疹和溼疹,症狀表現有大不同的
溼疹和尿布疹最大的區別就是兩者帶來的症狀表現不同,尿布疹般多發坐在嬰幼兒的臀部或者是外陰等部位,會出現紅斑或者丘疹的情況,而溼疹剛開始發展的時候,面板損位最大的表現一般是出現米粒或黃豆大小的丘皰疹,後期可能會出現和苔蘚一樣的情況。尿布疹圖片尿布疹一般指尿布皮炎,又名紅臀,主要發生在一歲內的寶寶身上,而且尤其是7-9個月大的寶寶,這種病症是大小便分解後所出現的氨傷害到臀部肌膚後所產生的特有現象,屬於...

一文解析冬天嬰兒溼疹造成原因,是不是熱引起的全說清
目前在臨床上發現嬰兒溼疹的誘因主要有兩類,一類是機體內在因素,如內分泌疾病、營養障礙、慢性感染、腫瘤等,在這些因素的影響下會導致嬰兒患有面板疾病,另一類是外在因素,嬰兒的腸胃功能較差,消化道攝入食物性變應原,如牛奶、魚、蝦、牛羊肉、雞蛋等致敏因素。嬰兒溼疹是怎麼引起的嬰兒溼疹是最常見的一種面板病,也稱為是奶癬,這類面板病感染部位較多,可以在肩胛部位出現乾性溼疹,也可以在其它部位,對於不同的部位,其...

嬰寶禁用了為什麼藥房還在賣?店員告知你背後真實原因
嬰寶在19年使用了酮康唑,酮康唑是一種抗菌藥,早在2015年6月份國家藥品監督管理局就釋出關於停止生產銷售使用酮康唑口服劑的公告,經過資料統計,發現酮康唑口服劑存在嚴重肝中毒不良反應,使用風險過大,所以決定進行停止,但嬰寶有在新增酮康唑,所以被國家禁止,採取了下架等措施。但之後諾必行也經過產品召回,進行了停業整改,之後的抽檢中也是合格的,不含違禁成分,所以說現在藥店又開始售賣諾必行嬰寶溼疹膏,在寶...

新生兒臉上溼疹祛除須知,這五種小妙招很實用!
新生兒出現溼疹是很常見的,尤其是對於0-6個月的新生兒,出現溼疹的機率是很高的。溼疹作為一種常見的面板病,發作起來是很難受的,又痛又癢的,對於剛出生的新生兒無非就是遭罪的表現,令不少媽媽都心疼不已。對於新生兒出現溼疹,很多的家長都是不知道如何是好的,尤其對於第一次接觸孩子的爸爸媽媽來說,更是手足無措了。所以今天我們就全面瞭解一下什麼是溼疹,以及為什麼會出現和應對小妙招。什麼是新生兒溼疹溼疹也可以叫...

嬰寶溼疹膏使用指南來了,寶寶這些部分可別塗
嬰寶溼疹膏不建議塗抹在腋下,外陰或者顏面等面板薄弱的地方,否則容易引起激素依賴性皮炎,嬰寶溼疹膏是一種治療溼疹的產品,主要通過抑菌、收斂,防止滲出、消除炎症從而達到治療效果,主要適用症有面板溼疹、小兒尿疹、乳疹、蚊蟲叮咬,面板過敏、汗溢溼疹、面板瘙癢等。嬰寶溼疹膏屬於沒有激素的,但另外絕大多數的溼疹膏裡面都含有一些弱效的激素,所以不能用在臉上的,腋下和外陰也要慎用,另外要注意溼疹膏不可長期過量的使...

從圖片上分析溼疹和熱疹的區別,靠顏色就能準確分辨
新生兒換季長的溼疹和熱疹的卻別主要是顏色有所不同,因為熱疹是由於氣溫過高而產生的的,等到氣溫下降之後就會消失的,而溼疹主要是有一些小顆粒,還伴隨著白色的皮屑,多數會出現在孩子的頭頂和耳朵旁邊,有的還會出現一些淡黃色的液體,一般是能夠從外觀上就區分出來的。溼疹或者熱疹多數都是由於溫度或者光線的變化,或者面板受到了其他的外部刺激,就會很容易出現一些疾病,溼疹和熱疹一般都多發生於換季的時候,特別是夏季氣...

帶你瞭解什麼牌的嬰寶是真的,購買請認準唯一正版
嬰寶正確的牌子是諾必行,其餘的例如諾必夫、諾必禾、諾必寧、皮衛等都是山寨產品,完全模仿諾必行的,名字相似,包裝也做得差不多,所以媽媽們在需要給寶寶用溼疹膏時,最好在大的實體店或者天貓官方旗艦店的購買諾必行嬰寶,以免買假貨上當。市場上治療溼疹的藥膏五花八門,比較多,一般的純中藥藥膏雖然不含有激素,但裡面中藥種類比較多,部分有刺激性比較大或者容易引起過敏的可能,反而在比較薄嫩的面板不宜使用,比如嬰兒、...

看了又看